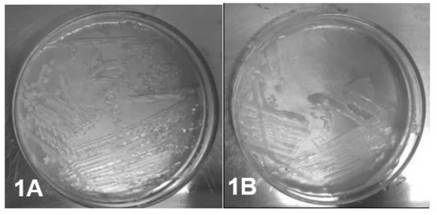

Artículos cortos
Evaluación de fijadores biológicos de nitrógeno libres sobre el crecimiento de gramíneas en suelo degradado
Evaluation of free nitrogen biological fixers on the growth of grasses on degraded soil
Evaluación de fijadores biológicos de nitrógeno libres sobre el crecimiento de gramíneas en suelo degradado
Revista Colombiana de Biotecnología, vol. XXII, núm. 1, pp. 87-97, 2020
Instituto de Biotecnología, Universidad Nacional de Colombia
Recepción: 22 Agosto 2019
Aprobación: 13 Abril 2020
RESUMEN: Los problemas de degradación del suelo que se presentan actualmente permiten que los fijadores biológicos de nitrógeno libre (FBNL), tengan potencial como microorganismos regeneradores de este recurso. Con el objetivo de evaluar su capacidad como grupo funcional, se buscó el aislamiento en medios selectivos Ashby y FBN. Luego de su caracterización morfológica y bioquímica; se inocularon dos tipos de semillas, Zea mays y Brachiaria decumbens; sembradas en un suelo degradado (predio La Ortega de la Universidad de Medellín). Se realizaron 4 tratamientos con 5 repeticiones, durante 36 días en invernadero. Los resultados más destacados los presentó la Brachiaria decumbens al incrementar el peso seco y la longitud de sus raíces gracias a un aislado FBNL (AshAssm4); lo que sugiere su potencial utilización para mejorar los procesos de revegetalización.
Palabras clave: Calidad del suelo, Fijación de nitrógeno, Crecimiento vegetal.
ABSTRACT: Due to the problems of soil degradation that currently occur, the free nitrogen biological fixers (FNBF), have potential as regenerating microorganisms of this resource. With the objective of evaluating its capacity as a functional group, isolation was sought in selective media Ashby and FBN; after its morphological and biochemical characterization; two types of seeds were inoculated, Zea mays and Brachiaria decumbens; planted in degraded soil (La Ortega property of the Universidad de Medellín). Four treatments were performed with 5 repetitions, during 36 days in the greenhouse. The most outstanding results are those described by Brachiaria decumbens by increasing the dry weight and the length of its roots thanks to a FNBF isolate (AshAssm4); which suggests its potential use to improve revegetalization processes.
Key words: Soil quality, Nitrogen fixation, Plant Growth.
INTRODUCCIÓN
Dentro de las principales funciones del suelo afectadas por su degradación, se encuentra el sostenimiento de la producción de biomasa y de biodiversidad, incluyendo la preservación y desarrollo de almacén de genes (Lal, 1997). El daño de los suelos por causas antrópicas es tan antiguo como la historia de la humanidad. La extensión de la degradación de los suelos y la consiguiente afectación al bienestar de las personas y al medio físico-natural, alcanza hoy proporciones alarmantes: el 33% del recurso suelo en el mundo se encuentra entre moderado y altamente degradado debido a la erosión, salinización, compactación, acidificación y a la contaminación química (FAO y GTIS, 2015). Esta degradación, socava la capacidad productiva de los ecosistemas (López-Falcón, 2002). En Latinoamérica el cambio climático y la presión humana, son algunos de los principales factores impulsores de la degradación del suelo, trayendo consigo la pérdida del carbono orgánico del suelo, la biodiversidad, y un desbalance de nutrientes; importantes en los niveles de producción de biomasa (FAO y GTIS, 2015).
Por otra parte, el nitrógeno es un elemento limitante para el crecimiento de especies vegetales, ya que su nivel de disponibilidad es bajo (Obando et al., 2010). Y ante el insuficiente nitrógeno disponible, habrá cantidades mínimas de clorofila, por lo que las plantas no podrán utilizar la luz del sol como fuente de energía para realizar funciones esenciales como la absorción de nutrientes (Salisbury y Ross, 1992).
Para mejorar la disponibilidad del nitrógeno, se emplean microorganismos fijadores de nitrógeno, dentro de los que se distinguen dos grupos: los microorganismos "simbióticos" que fijan nitrógeno en asociación con plantas, estos microrganismos llamados rizobios colonizan y forman nódulos en las raíces de las plantas donde el nitrógeno gaseoso se reduce a amonio; y los microorganismos de tipo "asimbióticos" (o de vida libre) que proporcionan al medio compuestos nitrogenados como amonio, aprovechados por los vegetales (Hernández, 1998; Zuberer, 1998). La tasa de fijación de nitrógeno de los rizobios simbióticos suele ser superior a la tasa de fijación por bacterias asimbióticas (Sevillano y Rodríguez, 1987; Reed et al., 2011). A pesar de esto, gracias a la disponibilidad de compuestos orgánicos procedentes de raíces, la tasa de fijación de nitrógeno de bacterias asimbióticas como Azotobacter es mayor en la rizosfera que en el suelo libre de raíces. Adicionalmente, la fijación de nitrógeno simbiótica, aunque sea más alta, está limitada a especies vegetales como las leguminosas. La elección de fijadores libres o asimbióticos se basa fundamentalmente por su interacción con las gramíneas.
Los microorganismos asimbióticos se encuentran prácticamente en todos los hábitats, como el suelo, el mar, fuentes de agua dulce y sedimentos. Uno de los géneros más utilizados como biofertilizantes es el Azotobacter sp (Jiménez, 2007) que tambien influye en el establecimiento de condiciones óptimas para el desarrollo de una cubierta vegetal estable. Esto es fundamental para que se conserve la calidad del suelo (Suquilanda, 1996). Muchos de los estudios que se han realizado van dirigidos a prácticas agrícolas y forestales, aislando microorganismos de diferentes ambientes, teniendo resultados positivos en cuanto a la producción de biomasa vegetal de gramíneas como el maíz y los pastos forrajeros. Los datos indican un 60 - 70% de ocurrencia de éxito con un incremento significativo en las cosechas del orden de 5 - 30%, esto atribuido al género Azospirillum (Okon y Labandera-Gonzalez, 1994). Otro estudio indica la alta fijación de nitrógeno a pH 6,8 y 35 °C por la especie Azospirillum brasilense en pastos (Lee, 1985). Del aislamiento de la rizósfera de cultivos de plátano, maíz y rastrojos; las concentraciones más altas del ión amonio exudado al medio, correspondió a 14 cepas del género Azotobacter con el valor de 5 mg l-1, (Lara et al., 2007). Tambien se ha visto aumento en la materia seca aérea de maíz inoculado con Azospirillum, en relación al maíz sin inóculo (Paredes, 2013).
Es pertinente entonces generar tecnologías basadas en el uso de microorganismos que promuevan procesos naturales como la fijación biológica de nitrógeno (FBN) ya que la mayor parte de este es fijado y directamente disponible en la naturaleza gracias a bacterias y otros microorganismos (Divan et al., 2008). Este proceso no sólo permite usar el nitrógeno atmosférico, sino también, revertir o mitigar la degradación del suelo (Mayz-Figueroa, 2004).
El suelo objeto de estudio se localiza en un predio de la Universidad de Medellín al occidente de la ciudad del mismo nombre. Es un suelo franco-arcilloso, con alta densidad aparente, una baja cantidad de materia orgánica, pH fuertemente ácido y una baja población de microorganismos (1*107 UFC/ml).
El objetivo de esta investigación es evaluar el efecto de un microorganismo fijador libre de nitrógeno (AshAssm4 del género Azotobacter) sobre el crecimiento de plantas modelo como el maíz ( Zea mays) y el pasto Brachiaria decumbens en un suelo degradado por medio de su aislamiento, caracterización, multiplicación e inoculación en semillas.
MATERIALES Y MÉTODOS
Aislamiento y purificación
A partir de granos de suelo de la zona (Guarne, Antioquia), técnica usada por Jiménez et al., (2011) y raíces (Osorio y Habte, 2013) de frijol cargamanto blanco, maíz criollo regional amarillo (Zea mays), lechuga y tomate sembrados en recipientes de 24 onzas; se aislaron microorganismos en medios de cultivo libres de nitrógeno como el Ashby y el medio para Fijadores Biológicos de Nitrógeno (FBN Sobiotech). Las cajas de Petri se incubaron a 34°C durante 24 - 48 horas. Pasado este tiempo se observaron y describieron morfologías de las colonias, y aquellas que fueron representativas se re-aislaron mediante siembra por agotamiento en los mismos medios para buscar un mejor desarrollo de estas.
Caracterización de aislados
Después de 4 días de incubación se volvió a observar crecimiento de colonias y aquellas que eran demasiado pequeñas o cuya línea de siembra no permitía diferenciarlas se descartaron y las que presentaron morfologías similares en forma, borde, elevación, superficie, consistencia, aspecto, color y tamaño a los microorganismos del género Azotobacter y Azospirillum se preservaron a 4°C. Se realizó siembra por agotamiento de aquellos aislados que fueran compatibles con fijadores libres de nitrógeno a los que además se les hizo la tinción de Gram estándar, la prueba de la catalasa, oxidasa, hidrólisis de almidón, SIM (Sulfuro Indol Motilidad) y oxidación/fermentación (O/F). Adicional a esto se aplicaron las galerías de identificación automática Api 20 NE (bioMérieux SA®) a colonias de los aislados sembrados en Agar Tripticasa Soya (TSA) siguiendo la metodología de inoculación e interpretación según el manual de dichas pruebas (Moreno, 2010).
Conservación
Los aislados purificados se transfirieron a tubos eppendorf con un contenido de medio líquido (Ashby y FBN) con Glicerol (85%) a un 30% de la solución total. Se llevaron a un refrigerador (<0°C) (Flores-Gallegos et al., 2012).
Muestreo y caracterización del suelo degradado
El lugar del muestreo se realizó en un terreno del predio La Ortega en la Universidad de Medellín, con coordenadas 6°13'51,96"N, 75°36'41,1"W; altitud de 1574 m.s.n.m. En forma de zigzag se tomaron 8 submuestras hasta tener un total de 40 kg de suelo homogéneo. En campo se determinó densidad aparente del suelo por el método del cilindro y se midió la pendiente. En laboratorio se halló el porcentaje de humedad y máxima capacidad de retención de humedad (MCRH). Además, se realizaron diluciones seriadas (10-5 y 10-7) de 10 gramos de suelo en agua peptonada bufferada para observar posibles microorganismos en desarrollo en agar Ashby. Se preparó 1 kg de suelo tamizado para analizar propiedades fisicoquímicas en el laboratorio de la Universidad de Nacional de Colombia. Las características del suelo se muestran en la tabla 1.

Los datos de la Tabla 1 indican condiciones iniciales del suelo que fueron necesarias para determinar la cantidad de agua que se adicionó para controlar la MCRH, dosis de inóculo y determinar que no se presentarán microorganismos diferentes al estudiado. La pendiente del 50%, se clasifica como escarpada, la cual se encuentra entre los valores de 30% y 60% definidos por la FAO (2009); la densidad aparente es alta al encontrarse por encima de 1,3 g/cm3, lo que indica un ambiente pobre para el crecimiento de raíces, aireación reducida y cambios indeseables en la función hidrológica como la reducción de la infiltración del agua (FAO, 2009). El conteo en placa reveló una baja población de UFC lo que indicaría una débil afectación de los tratamientos a utilizar.
Con base en los resultados del análisis del suelo (Tabla 2) especialmente los valores de pH, M. O, Al, K, P, S y CICE, se clasifica a este suelo como degradado. La CICE es baja lo que se traduce en un suelo pobre que necesita aporte de materia orgánica (Garrido, 1994). La clase textural corresponde a franco arcillosa, en donde no hay proporción dominante de algún separado sobre las propiedades del suelo pero en donde la arcilla puede ejercer una mayor retención de humedad e impartir cualidades plásticas al suelo (Jaramillo, 2002). El valor de pH se clasifica como fuertemente ácido (USDA, 1993). Se debe entonces hacer un proceso de restauración, propiciando el desarrollo vegetal mediante la acción de microorganismos benéficos como los FBNL.

(Laboratorio de suelos Universidad Nacional de Colombia)
Bioaumento
Para la multiplicación del aislado (AshAssm4) se utilizó caldo Ashby (200 ml) incluidos los 20 ml (10% de la solución total) de solución peptonada bufferada al 0,1% con una concentración igual al patrón de McFarland 0,5 que es aproximadamente igual a tener 1,5*108 bacterias/ml. El medio se llevó a agitación durante 48 horas a 120 rpm y a 30°C modificado de (Brusamarello-Santos et al., 2017; Borda-Molina, Pardo-García, Martínez-Salgado, y Montaña-Lara 2009).
Bioensayo
Con el suelo previamente tamizado se prepararon los recipientes de 24 oz, con 600 g de suelo cada uno. Se continuó con la desinfección de las semillas de Zea mays (maíz) y Brachiaria decumbens; sumergiéndolas por 30 segundos en solución de etanol al 70% v/v y luego por 2 minutos en hipoclorito de sodio al 2%. Se finalizó con 3 lavadas usando agua destilada estéril.
Fueron sembradas 15 semillas de Brachiaria decumbens y 3 de Zea mays (maíz) por recipiente. Se aplicaron 4 tratamientos con 5 repeticiones cada uno, los cuales fueron: control positivo (adición de fuente de Nitrógeno en forma de Urea, 0,8g/100ml) 5 ml por recipiente, control negativo (adición de caldo Ashby sin inóculo) 1 ml por recipiente, microorganismo FBNL 1 ml por recipiente y un tratamiento con FBNL + Urea, 1ml y 5 ml respectivamente. Todos estos recipientes fueron llevados al invernadero y se controló la MCRH (5060%) mediante la adición de agua destilada estéril.
Cuantificación de biomasa vegetal
Para determinar el efecto sobre la biomasa vegetal las variables controladas fueron la altura y el peso. Se midió la altura de brotes tanto del maíz como de la Brachiaria decumbens a los 20 y 36 días del ensayo en invernadero. También se obtuvo medición de longitud de raíces en el último día, cuando se desmontaron las unidades experimentales. Se pesó en balanza analítica el peso fresco de brotes y raíces de ambas especies vegetales estudiadas. Para el peso seco se llevó a estufa por 48 horas a 70°C.
Análisis de datos
Se realizó un análisis de varianza con un nivel de significancia de α 0,05 empleando el software SAS System 8e. Se verificó normalidad de los datos por medio de la distribución al azar de los tratamientos e igualmente se evaluó el supuesto de homogeneidad de varianzas y correlación de los datos.
RESULTADOS Y DISCUSIÓN
Aislado y caracterización de posibles FBNL
En la tabla 3 se listan los aislados que por su crecimiento colonial fueron representativos y compatibles con los géneros Azotobacter y Azospirillum. Es válido mencionar que no todas las colonias en raíces y granos de suelo crecieron o fueron compatibles, tales como las de tomate en el medio FBN y las raíces de lechuga en medio Ashby.

Se encontró un total de 23 aislados compatibles con FBNL para continuar con su caracterización. La figura 1A muestra el crecimiento de colonias del aislado FBNAsrm2 en medio libre de nitrógeno mediante siembra por agotamiento. La figura 1B es el aislado AshAssm4 en agar Ashby luego de 4 días a 34°C en crecimiento. Ambos aislados son compatibles con fijadores libres de nitrógeno.
Figura 1
Colonias de dos aislados sembrados en los medios FBN (1A) y Ashby (1B)
En la tabla 4 se encuentran los resultados para aquellos aislados que crecieron en agar TSA, y a los cuales se les realizó pruebas complementarias (Gram, catalasa, oxidasa, SIM, hidrólisis de almidón y O/F) a las de la galería API 20NE (bioMérieux SA®). El aislado AshAssm4 fue compatible con la especie Azotobacter vinelandii presente en el biofertilizante (TerraVite-S21®) y por ser el único con ureasa positiva, resultado compatible para los géneros bacterianos utilizados como referentes con el Manual de Bergey de Bacteriología Sistemática (Garrity, 1984).

En la figura 2 se aprecia la caracterización microscópica del aislado AshAssm4 proveniente de granos de suelo de maíz; el cual presenta forma de bacilo corto, gram negativo, agrupándose en pares y con la formación de quistes. Todas estas características propias del género Azotobacter (Garrity, 1984).

Figura 2
Observación al microscopio de tincón de Gram ( 100X)
Concentración final del bioaumento
Se realizó a partir de diluciones seriadas, inoculando la dilución de 10-5 y 10-7 por triplicado en agar Ashby; se llevó a incubación 34°C durante 5 días. El conteo final fue de 2,4*108 UFC/ml para la dilución 10-5 y 8*108 UFC/ml para la dilución 10-7.
Determinación de variables respuesta
Las figuras 3, 4, 5 y 6 muestran los resultados estadísticamente significativos para las variables estudiadas que obtuvieron un valor p<0,05 y también los tratamientos que reflejan valores promedio de interés así no hayan tenido diferencias significativas entre sí. La prueba de Tukey (p<0,05) fue utilizada para saber cuáles fueron las medias con diferencias significativas entre tratamientos.

Figura 3
Efecto de la aplicación de FBNL sobre la altura en cm de brotes de Brachiaria decumbens a los 20 días (Fig 3A) y a los 36 días (Fig 3B). Medias con diferente letra son significativamente diferentes.

Figura 4
Efecto de la aplicación de FBNL sobre la longitud en cm de raíces de maíz (Zea mays) (Fig 4A) y Brachiaria. decumbens (Fig 4B). Medias con diferente letra son significativamente diferentes.

Figura 5
Efecto de la aplicación de FBNL sobre el peso fresco en gramos de los brotes de Brachiaria decumbens. Medias con diferente letra son significativamente diferentes.

Figura 6
Efecto de la aplicación de FBNL sobre el peso seco en gramos de brotes (Fig 6A) y raíces (Fig 6B) de Brachiaria decumbens. Medias con diferente letra son significativamente diferentes.
La figura 3 muestra los diferentes valores de altura que manifestaron las plantas de Brachiaria decumbens. Se hizo un seguimiento en dos momentos del ensayo, los cuales reflejan un aumento progresivo de la altura con el tiempo y consiguiéndose un valor numérico mayor para el tratamiento en el que se añadió el inóculo (microorganismo AshAssm4) y la dosis de urea.
Lo anterior indica una relación benéfica entre el FBNL y el nitrógeno inorgánico agregado, considerándose así la posibilidad de sustituir parcialmente las dosis aplicadas de fertilizante al suelo (Lara et al., 2007). Cantidades que se pueden reducir entre un 20 a 50% (Méndez, Castro y García, 2015). A pesar de que el valor p de 0,4524 y de 0,1076 para la figura 3A y 3B, respectivamente son mucho mayores al valor de significación α de 0,05; se presentó un aumento en la altura del 20,88% a los 20 días y del 11,2% a los 36 días gracias al uso de FBNL respecto al control positivo (adición de nitrógeno en forma de urea). Un resultado importante para el maíz se dio en la longitud que experimentaron las raíces en el tratamiento con el microorganismo FBNL mostrado en la figura 4A, seguido por el FBNL + urea. Aunque no se presentaron diferencias significativas entre los tratamientos, el efecto que ejerció la aplicación del inóculo FBNL con respecto a la adición de urea se representó en un incremento del 13,75% en esta variable. Puede ser que el crecimiento se deba a fitohormonas que inducen el alargamiento de la raíz ya que el género Azotobacter pertenece a las PGPR (Plant Growth Promoting Rhizobacteria) que estimula el desarrollo vegetal y unido a la fijación de nitrógeno incrementa el rendimiento de gramíneas (Díaz et al., 2001).
En contraste a esto la Brachiaria (figura 4B) sí mostró diferencias significativas entre el tratamiento FBNL y el control positivo con un valor p de 0,0047 el que es menor al nivel de significación α de 0,05 lo cual se considera estadísticamente significativo y con la posibilidad de aceptar que hay un efecto positivo del microorganismo sobre la longitud de las raíces.
La figura 5 indica que el tratamiento que mejor estimuló el peso fresco de la parte aérea del pasto (Brachiaria decumbens) fue el empleo de inóculo más adición de urea seguido de sólo el inóculo; el no tener diferencias significativas entre tratamientos (valor p de 0,1885 mayor a la significancia estadística α de 0,05) no elimina la posibilidad de considerar el efecto que manifestó el FBNL, ya que incrementó en un 43,2% el peso fresco con respecto al control positivo.
Tal como lo menciona Guzmán et al. (2012), el crecimiento de la planta pudo haber dependido de la capacidad de Azotobacter en lograr un establecimiento alrededor de las raíces seguido de su capacidad para suministrar nutrientes. El notable desarrollo en el peso de los brotes coincide con los resultados que se obtuvieron con la aplicación de cepas nativas del género Azotobacter en semillas del pasto angleton (Dichanthium aristatum) donde se demostró que el 67,66% de material vegetal inoculado tuvo un mayor promedio de alturas de tallo, longitud de hojas y un notable desarrollo vegetativo de la planta (Lara et al., 2011).
De manera similar, la figura 6 presenta el contraste en la evaluación del peso seco para brotes y raíces de Brachiaria decumbens, ya que para este (figura 6B) se presentaron diferencias significativas en comparación a los brotes. Con un valor p de 0,0438 hay significancia estadística entre los tratamientos. La mayor efectividad fue para FBNL lo que indica un mayor rendimiento en la producción de materia seca debida a la actividad que ejerció el microorganismo compatible con el género Azotobacter.
El peso seco de los brotes (figura 6A) mostró un comportamiento similar pues los tratamientos inoculados fueron los más efectivos, en especial el que se acompañó con urea. Aunque no se hayan presentado diferencias significativas (valor p de 0,2192), no se descarta el buen funcionamiento que el FBNL (sin acompañamiento de urea) presentó, porque incrementó en un 41,25% el peso con relación al control positivo. Valores indicativos de una mejor eficiencia del microorganismo y su relación suelo-planta.
En síntesis, hay relación de los resultados obtenidos en la altura de Brachiaria con el peso seco y fresco de sus brotes, ya que estas variables mostraron el mismo comportamiento alcanzando efectos deseables cuando se usó el tratamiento con los FBNL + urea seguido del que sólo contenía FBNL. El maíz por su parte mejoró la longitud de su raíz gracias al tratamiento con el FBNL.
La influencia de las características del suelo tales como el pH (fuertemente ácido), la baja cantidad de materia orgánica y la alta densidad aparente, pudieron afectar el crecimiento de las plantas de maíz debido a las malas condiciones que se tuvieron para que los microorganismos se hubieran logrado establecer. A diferencia de las plantas de Brachiaria decumbens, la cual gracias a su buena adaptabilidad a suelos ácidos de baja fertilidad como los que hay en el trópico (Rao et al., 1998), al buen crecimiento radical y al poder adquirir el nitrógeno mediante fijación asociativa (Dalton y Kramer, 2007), presentó resultados significativos.
CONCLUSIONES
Se aislaron 23 microorganismos compatibles con fijadores biológicos de nitrógeno libres cuyo potencial biotecnológico puede aprovecharse en el estudio de sus capacidades como promotores del crecimiento vegetal.
El aislado AshAssm4 caracterizado como Azotobacter vinelandii promovió el desarrollo en la longitud de raíces de maíz, hecho influenciado por las dinámicas propias de las PGPR en cuanto a la liberación de sustancias que incrementan el desarrollo de la parte radicular y la fijación de nitrógeno; un funcionamiento particular, considerando el hecho de que el suelo tiene un déficit de nutrientes y materia orgánica asociada. Por su parte, la Brachiaria decumbens presentó un nivel significativo de rendimiento en sus raíces, que muestra su potencial de desarrollarse y adaptarse mejor a suelos ácidos. Se prueba la actividad del género Azotobacter como un fijador libre que promueve el desarrollo en este tipo de pastos. Los resultados en cuanto a peso seco de raíces y brotes indican un crecimiento del material vegetal que puede propiciar la generación de materia orgánica, y por consiguiente la propagación de microorganismos benéficos, retención de humedad y balance de nutrientes en suelos degradados que necesitan ser recuperados como soporte para los ecosistemas y actividades humanas. Esta investigación aporta al enriquecimiento de prácticas en la restauración de suelos degradados a partir de la utilización de microorganismos fijadores de nitrógeno libre en gramíneas. Con un enfoque ambiental de la biotecnología se espera a futuro la elección de técnicas biológicas en la recuperación de suelos mediante procesos de revegetalización y la evaluación de su desempeño en la mejora de la calidad del recurso.
AGRADECIMIENTOS
Quiero agradecer a todo el grupo operativo del laboratorio Sobiotech S.A.S., a los profesores Jacqueline López y Octavio González por su confianza y acompañamiento. Igualmente, a la Universidad de Medellín y a su grupo de investigación GRINBIO por todo el conocimiento y apoyo recibido.
BIBLIOGRAFÍA
Borda-Molina, D., Pardo-García, J. M., Martínez-Salgado, M. M., & Montaña-Lara, J. S. (2009). Producción de un biofertilizante a partir de un aislamiento de Azotobacter nigricans obtenido en un cultivo de Stevia rebaudiana Bert. Universitas Scientiarum, 14 (1), 71 -78.
Brusamarello-Santos, L. C., Gilard, F., Brulé, L., Quilleré, I., Gourion, B., Ratet, P., ... Hirel, B. (2017). Metabolic profiling of two maize (Zea mays L.) inbred lines inoculated with the nitrogen fixing plant-interacting bacteria Herbaspirillum seropedicae and Azospirillum brasilense. PloS One, 12(3), e0174576.
Dalton, D. A., & Kramer, S. (2007). Nitrogen-fixing bacteria in non-legumes. In Plant-Associated Bacteria (pp. 105-130). Springer, Dordrecht. http://doi.org/https://doi.org/10.1007/978-1-4020-4538-7_3.
Díaz Vargas, P., Ferrera Cerrato, R., Almaraz Suárez, J. J., & Alcantar Gonzalez, G. (2001). Inoculación de bacterias promotoras de crecimiento en lechuga. Terra Latinoamericana, 19(4).
Divan, V., Silva, J., dos Santos, K., Baldani, J., & Massena, V. (2008). Inoculants base on nitrogen-fixing bactéria Azospirillum spp. and their application in tropical agriculture. Asociación Argentina de Microbiología, BA, 227-237.
FAO. (2009). Guía para la descripción de suelos (4ta ed.). Roma: FAO. Retrieved from http://www.fao.org/3/a-a0541s.pdf.
FAO, & GTIS. (2015). Estado mundial del recurso suelo. Resumen Técnico. (L. Caon, N. Forlano, M. Keene, A. Sorokin, I. Verbeke, & C. Ward, Eds.). Roma: FAO .
Flores-Gallegos, A. C., Contreras-Esquivel, J. C., Reyes-Valdés, M. H., & Rodríguez-Herrera, R. (2012). Aislamiento e identificación de cepas nativas del suelo mexicano del género Azotobacter. Revista Científica de La Universidad Autónoma de Coahuila, 4(8).
Garrido, S. (1994). Interpretación de análisis de suelos. Ministerio de Agricultura, Pesca y Alimentacion.
Garrity, G. (1984). Bacteriología sistemática. (B. J. Don, K. Noel, R. Castenhonz, D. Bonne, & J. Staley, Eds.) (Vol. 1). New York: Springer.
Guzmán, A., Obando, M., Rivera, D., & Bonilla, R. (2012). Selección y caracterización de rizobacterias promotoras de crecimiento vegetal (RPCV) asociadas al cultivo de algodón (Gossypium hirsutum). Revista Colombiana de Biotecnología, 14(1), 182-190.
Hernández, Y. (1998). Bacterias fijadoras asimbióticas de nitrógeno. Revista Cubana de Ciencias Agrícolas, 32.
Jaramillo, D. (2002). Introducción a la ciencia del suelo. Medellín: Universidad Nacional de Colombia. Retrieved from http://www.bdigital.unal.edu.co/2242/V70060838.2002.pdf.
Jiménez Avella, D. J. (2007). Caracterización molecular de cepas nativas colombianas de Azotobacter spp. mediante el análisis de restricción del DNA ribosomal 16s. Pontificia Universidad Javeriana.
Jiménez, D. J., Montaña, J. S., & Martínez, M. M. (2011). Characterization of free nitrogen fixing bacteria of the genus Azotobacter in organic vegetable-grown Colombian soils. Brazilian Journal of Microbiology, 42(3), 846-858.
Lal, R. (1997). Agronomic impact of soil degradation. Methodology for Assessment of Soil Degradation. Boca Raton Florida: CRC Press.
Lara, C., Oviedo, L. E., & Betancur, C. A. (2011). Bacterias nativas con potencial en la producción de ácido indolacético para mejorar los pastos. Zootecnia Tropical, 29(2), 187-194.
Lara, C., Villalba, M., & Oviedo, L. E. (2007). Bacterias fijadoras asimbióticas de nitrógeno de la zona agrícola de San Carlos. Córdoba, Colombia. Revista Colombiana de Biotecnología, 9(2), 6-14.
Lee, K. C. (1985). Studies on nitrogen fixation of forage grasses in Taiwan. Proc. Int. Grassl. Congr.,15th, Kyoto, Jpn. 24-31 Aug.1985, 467-469.
López-Falcón, R. (2002). Degradación del Suelo, causas, procesos, evaluación e investigación (2da ed.). Mérida: CIDIAT-ULA.
Mayz-Figueroa, J. (2004). Fijación biológica de nitrógeno. Revista Científica UDO Agrícola, 4(1), 1 -20. Retrieved from https://dialnet.unirioja.es/servlet/articulo?codigo=2221548.
Méndez, M., Castro, E., & García, E. (2015). Azospirillum una rizobacteria con uso potencial en la agricultura. Biológicas Revista de La DES Ciencias Biológico Agropecuarias Universidad Michoacana de San Nicolás de Hidalgo, 16(1), 11-18.
Moreno, L. M. (2010). Caracterización de las cepas ICA L9 e ICA J96, de bacterias simbióticas fijadoras de nitrógeno y pruebas de estabilidad de inoculantes elaborados para cultivos de arveja y soya. Pontificia Universidad Javeriana.
Obando, D., Burgos, L., Rivera, D., Rubiano, M., Bonilla, R., & Divan, V. (2010). Caracterización de bacterias diazotróficas asimbióticas asociadas al eucalipto (eucalyptus sp.) en codazzi, cesar. Acta Biológica Colombiana, 15(3), 107-120.
Okon, Y., & Labandera-Gonzalez, C. A. (1994). Agronomic applications of Azospirillum: an evaluation of 20 years worldwide field inoculation. Soil Biology and Biochemistry, 26(12), 1591-1601. http://doi.org/https://doi.org/10.1016/0038-0717(94)90311-5.
Osorio, N. W., & Habte, M. (2013). Synergistic effect of a phosphate-solubilizing fungus and an arbuscular mycorrhizal fungus on leucaena seedlings in an Oxisol fertilized with rock phosphate. Botany, 91 (4), 274-281.
Paredes, M. C. (2013). Fijación biológica de nitrógeno en leguminosas y gramíneas. Trabajo Final de Ingeniería en Producción Agropecuaria. Pontificia Universidad Católica Argentina.
Rao, I. M., Kerridge, P. C., & Macedo, M. C. M. (1998). Requerimientos nutricionales y adaptación a los suelos ácidos de especies de Brachiaria. In Brachiaria: Biología, agronomía y mejoramiento (pp. 58 -78). CIAT.
Reed, S. C., Cleveland, C. C., & Townsend, A. R. (2011). Functional ecology of free-living nitrogen fixation: a contemporary perspective. Annual Review of Ecology, Evolution, and Systematics, 42, 489-512.
Salisbury, F., & Ross, C. W. (1992). Fisiología vegetal (pp. 319-338). México: Grupo Editorial Iberoamérica.
Sevillano, F., & Rodríguez, C. (1987). Sistemas simbióticos fijadores de nitrógeno de interés aplicado en agricultura. Avances En La Biología de La Fijación de Nitrógeno Atmosférico. Eds: M. Megías Y I. Ruiz, 9-29.
Suquilanda, M. (1996). Agricultura orgánica: alternativa tecnológica del futuro. (E. Fundagro, Ed.). Quito: Fundación para el desarrollo agropecuario.
USDA. (1993). Soil Survey Division Staff (1993) Soil Survey Manual. Soil Conservation Service. US Department of Agriculture Handbook, 18, 315.
Zuberer, D. (1998). Biological Dinitrogen Fixation: Introduction and Nonsymbiotic. En principles and applications of soil microbiology. In Biological Dinitrogen Fixation: Introduction and Nonsymbiotic. En principles and applications of soil microbiology. New Jersey: Prentice Hall.